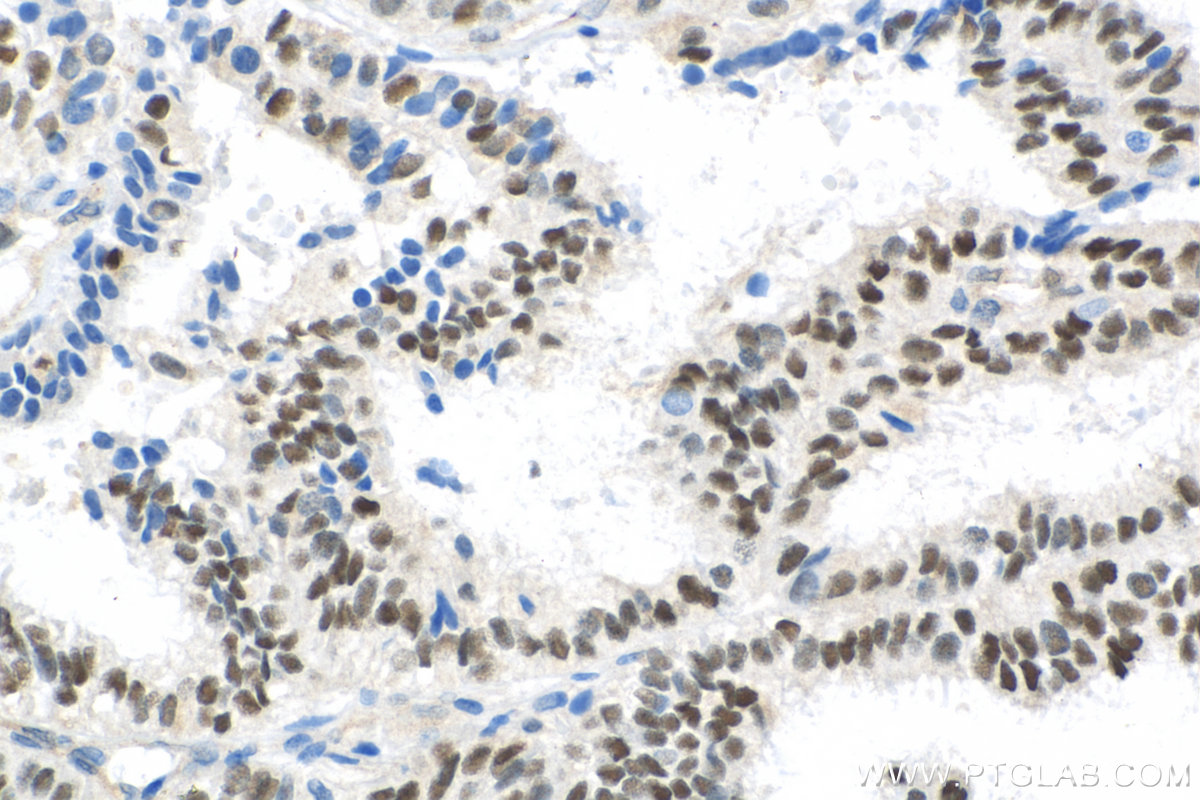
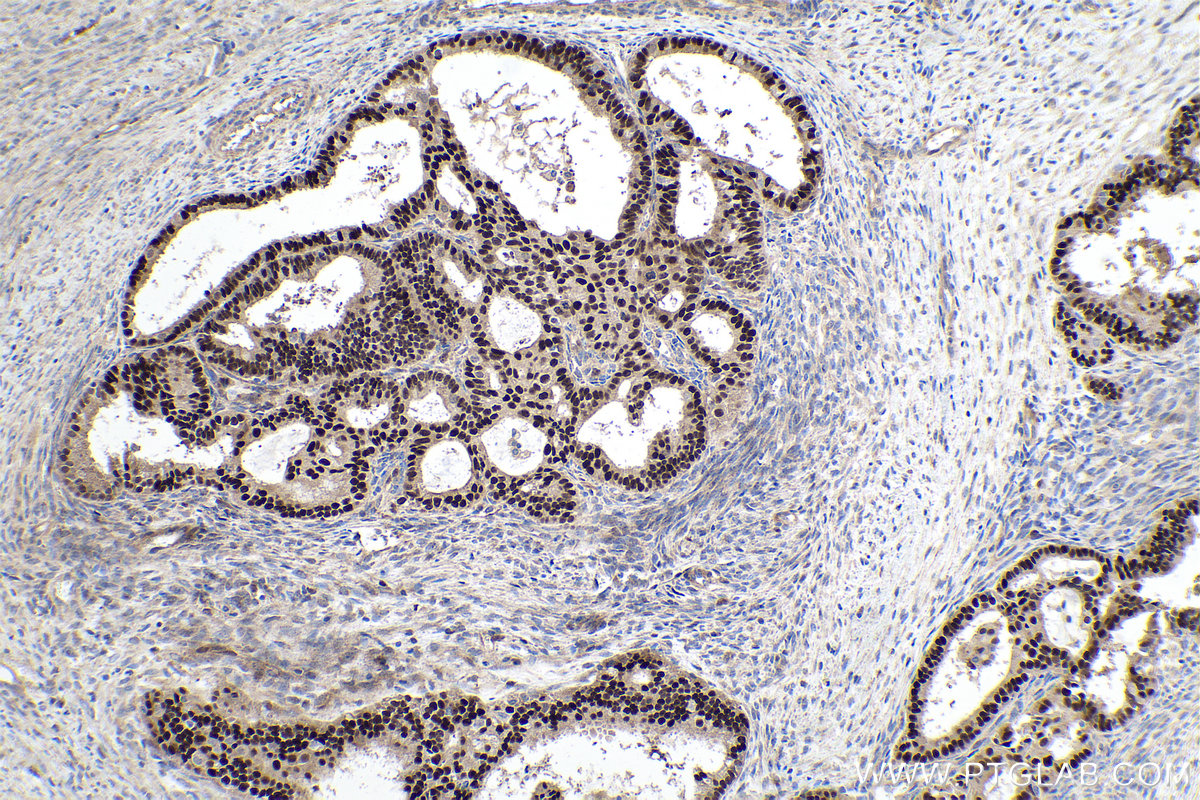

验证数据展示
经过测试的应用
| Positive WB detected in | LNCaP cells, C6 cells, MCF-7 cells, NIH/3T3 cells, Neuro-2a cells, mouse lung tissue |
| Positive IHC detected in | human ovary tumor tissue, human oesophagus cancer tissue, human lung cancer tissue, mouse spleen tissue, mouse pancreas tissue Note: suggested antigen retrieval with TE buffer pH 9.0; (*) Alternatively, antigen retrieval may be performed with citrate buffer pH 6.0 |
| Positive IF/ICC detected in | MCF-7 cells, NIH/3T3 cells |
| Positive FC (Intra) detected in | SH-SY5Y cells, MCF-7 cells |
推荐稀释比
| 应用 | 推荐稀释比 |
|---|---|
| Western Blot (WB) | WB : 1:5000-1:50000 |
| Immunohistochemistry (IHC) | IHC : 1:750-1:3000 |
| Immunofluorescence (IF)/ICC | IF/ICC : 1:400-1:1600 |
| Flow Cytometry (FC) (INTRA) | FC (INTRA) : 0.40 ug per 10^6 cells in a 100 µl suspension |
| It is recommended that this reagent should be titrated in each testing system to obtain optimal results. | |
| Sample-dependent, Check data in validation data gallery. | |
产品信息
26939-1-AP targets Cyclin D1 in WB, IHC, IF/ICC, FC (Intra), ELISA applications and shows reactivity with human, mouse, rat samples.
| 经测试应用 | WB, IHC, IF/ICC, FC (Intra), ELISA Application Description |
| 文献引用应用 | WB, IHC, IF |
| 经测试反应性 | human, mouse, rat |
| 文献引用反应性 | human, mouse, rat, pig, canine, bovine, sheep, goat |
| 免疫原 | Cyclin D1 fusion protein Ag25393 种属同源性预测 |
| 宿主/亚型 | Rabbit / IgG |
| 抗体类别 | Polyclonal |
| 产品类型 | Antibody |
| 全称 | cyclin D1 |
| 别名 | CCND1, B cell lymphoma 1 protein, B-cell lymphoma 1 protein, BCL-1, BCL-1 oncogene |
| 计算分子量 | 295 aa, 34 kDa |
| 观测分子量 | 34 kDa |
| GenBank蛋白编号 | BC000076 |
| 基因名称 | Cyclin D1 |
| Gene ID (NCBI) | 595 |
| RRID | AB_2880691 |
| 偶联类型 | Unconjugated |
| 形式 | Liquid |
| 纯化方式 | Antigen affinity purification |
| UNIPROT ID | P24385 |
| 储存缓冲液 | PBS with 0.02% sodium azide and 50% glycerol, pH 7.3. |
| 储存条件 | Store at -20°C. Stable for one year after shipment. Aliquoting is unnecessary for -20oC storage. |
背景介绍
CCND1 (cyclin D1), also known as PRAD1 or BCL1, belongs to the highly conserved cyclin family, whose members are characterized by a dramatic periodicity in protein abundance throughout the cell cycle. CCND1 forms a complex with and functions as a regulatory subunit of CDK4 or CDK6, whose activity is required for cell cycle G1/S transition. The CCND1 gene, located on 11q13 has been reported to be overexpressed in mantle cell lymphoma (MCL) due to the chromosomal translocation. CCND1 has been shown to interact with tumor suppressor protein Rb and the expression of this gene is regulated positively by Rb. Over-expression of CCND1 is known to correlate with the early onset of cancer and risk of tumor progression and metastasis. Cyclin D1 may have a molecular weight of 45kDa due to SUMO modification.
实验方案
| Product Specific Protocols | |
|---|---|
| WB protocol for Cyclin D1 antibody 26939-1-AP | Download protocol |
| IHC protocol for Cyclin D1 antibody 26939-1-AP | Download protocol |
| IF protocol for Cyclin D1 antibody 26939-1-AP | Download protocol |
| Standard Protocols | |
|---|---|
| Click here to view our Standard Protocols |
发表文章
| Species | Application | Title |
|---|---|---|
Mol Cancer LncRNA TROJAN promotes proliferation and resistance to CDK4/6 inhibitor via CDK2 transcriptional activation in ER+ breast cancer. | ||
Adv Sci (Weinh) Transgelin Promotes Glioblastoma Stem Cell Hypoxic Responses and Maintenance Through p53 Acetylation | ||
J Pineal Res Melatonin modulates metabolic remodeling in HNSCC by suppressing MTHFD1L-formate axis. | ||
Theranostics Histone H3K27 methyltransferase EZH2 regulates apoptotic and inflammatory responses in sepsis-induced AKI | ||
Nat Commun Identification of predictors of drug sensitivity using patient-derived models of esophageal squamous cell carcinoma. | ||
J Exp Clin Cancer Res ACTN1 promotes HNSCC tumorigenesis and cisplatin resistance by enhancing MYH9-dependent degradation of GSK-3β and integrin β1-mediated phosphorylation of FAK |